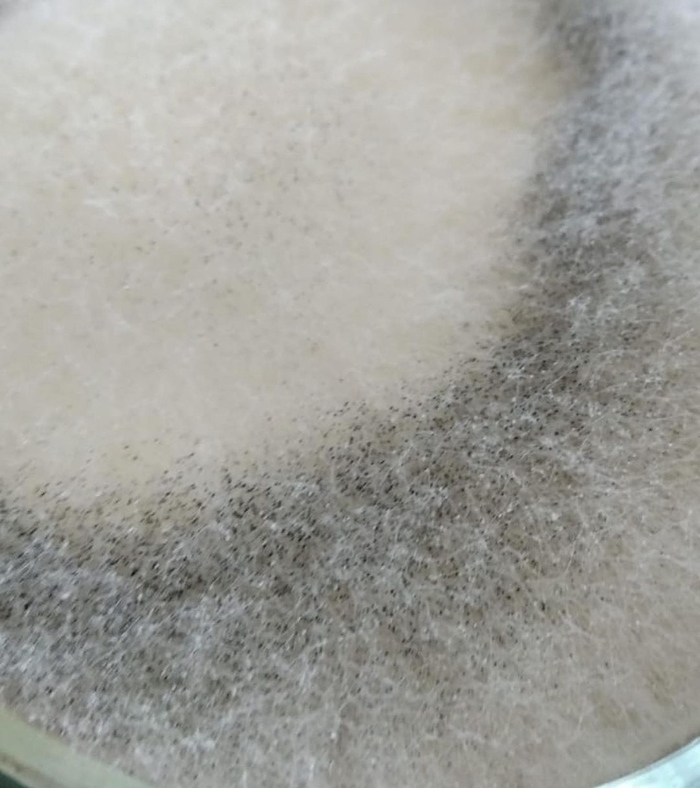
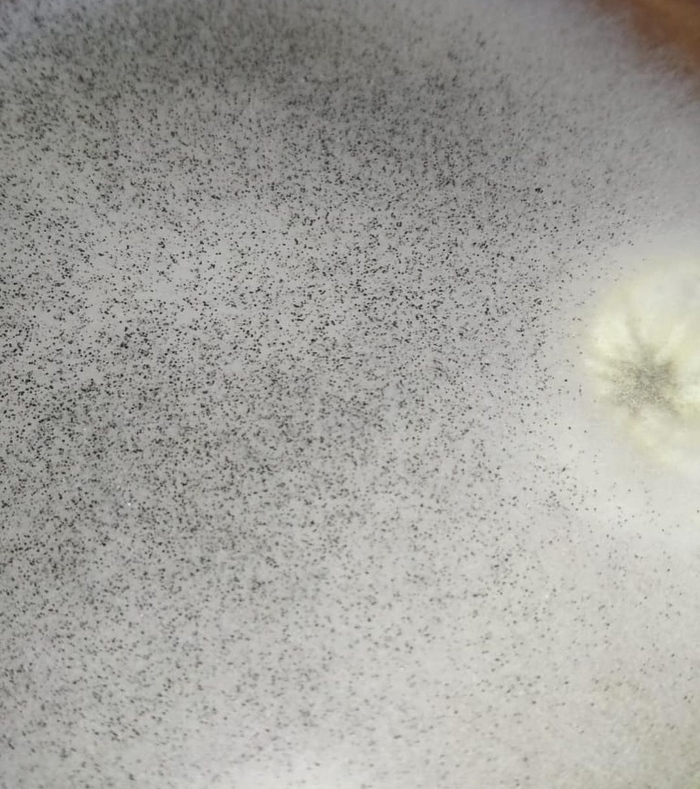
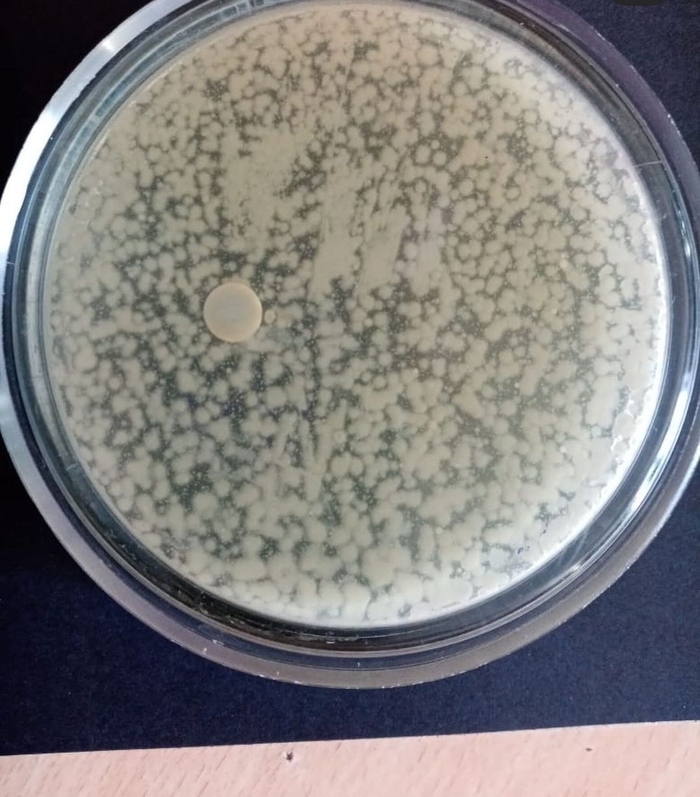
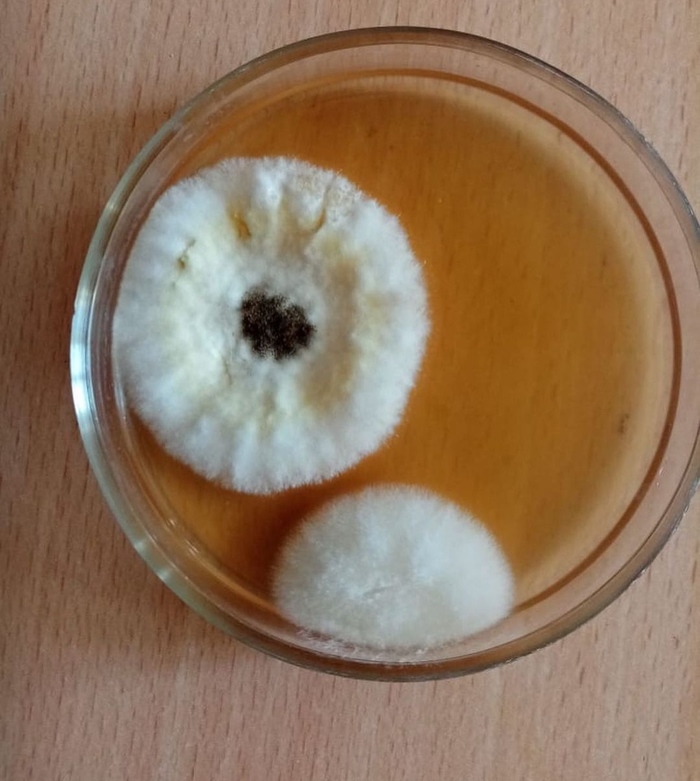
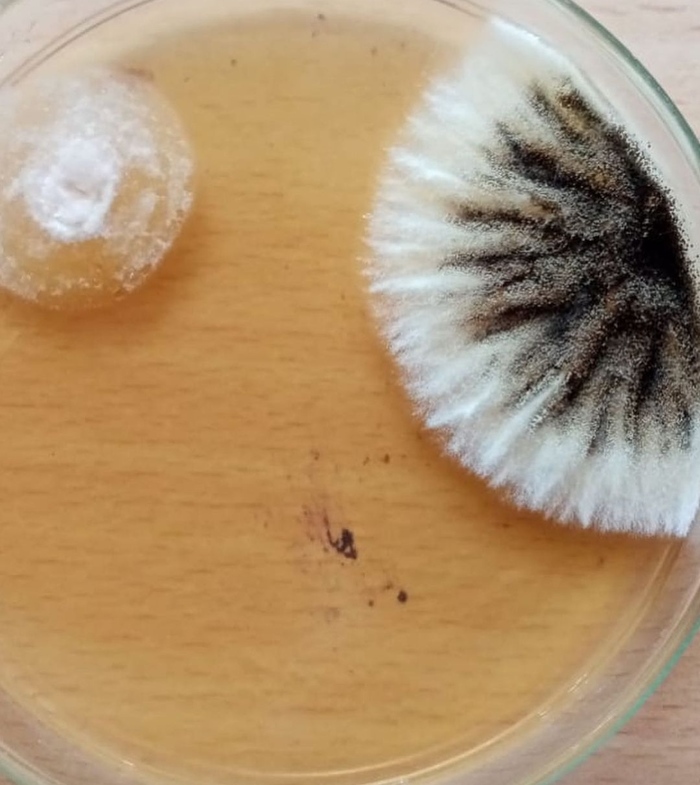

ZefZef
Насколько чисты маски
В одном университете города XXX. решили проверить насколько «чиста» новая маска купленная в аптеке.
Взяли новую маску и сделали смыв с участка 25/25 мм внутренней поверхности маски.
Спустя сутки после посева смыва с НОВОЙ КУПЛЕННОЙ В АПТЕКЕ маски - вырос МУКОР (слайд 1,2 и слайд 3-спорангий мукора под микроскопом).
На этом исследования не закончили и решили посмотреть, что может вырасти на образце маски , которую носили 2 часа. Сделали смыв с внутренней поверхности маски спустя 2 часа носки.
В итоге опытным путём обнаружили:
1). бактерии род Bacillus (слайд 4,5) - 1 единица бактерий даёт 1 колонию;
2). плесневелый гриб Aspergillus (слайд 6,7)
Таким образом, маска представляет собой непосредственную опасность.
Работа не закончена. В ближайшее время будут написаны статьи по этим работам.